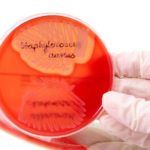
Стафілокок при вагітності: діагностика та лікування

Можна їсти лимон при грудному вигодовуванні?
Зміст:Користь лимона для годуючих мамШкода лимонаЯк правильно їсти лимон при грудному вигодовуванніАльтернативна думка на харчування мами під час ГВЯк є лимон при годуванні грудьмиЛимон відноситься до цитрусових фруктів і традиційно вважається алергеном.
Суп із сочевиці годуючій мамі
Зміст:Користь сочевиціЩо можна приготувати з сочевиціПродукти, до складу яких входить велика кількість білка, дуже важливі для повноцінного харчування молодої мами.
Втягнуті соски у жінок: причини, корекція
Зміст:Що це такеПровокуючі факториВправи для усунення проблемиХірургічне лікуванняЩо робити, щоб налагодити грудне вигодовуванняВисновокВтягнуті соски – це особлива будова грудей, при якому ареола виявляється втопленою в залозу.
Чоловік-лев і жінка-скорпіон: сумісність в любові і шлюбі
Сумісність в любові Вогненним левам притаманні бійцівські якості, агресивність. Вони генетично запрограмовані на конфлікти, прояв агресії, грубе домінування. Владні люди побоюються близьких духовних відносин,...
Показання до медикаментозної стимуляції овуляції: перелік препаратів
Зміст:Необхідність стимуляціїПідготовчий етапПерелік медикаментівКлостилбегітПурегонХорагонДюфастонЛетрозолВітамінотерапіяПротипоказання і побічні ефектиУ питаннях планування вагітності значення мають будь-які дрібниці.
Про що свідчить підвищений рівень еозинофілів в крові у дитини
Зміст:Що таке еозинофілиНорми еозинофілів у дітейПро що свідчить підвищений рівень еозинофілівПричини підвищення еозинофілів у новонародженихЕозинофіли і інші показники кровіВизначення рівня еозинофілівСитуація, коли у дитини підвищені еозинофіли, зустрічається досить часто.
Дитяче придане: що і в якій кількості купуватиме перед народженням дитини
Майбутні матусі, які не вірять у прикмету про те, що не можна заздалегідь купувати дитячі речі, з любовю готують придане для малюка. А так як в магазинах дитячих товарів очі буквально розбігаються від різноманіття, є ризик придбати більше, ніж потрібно.Що потрібно дитині в придане? – спантеличилася питанням майбутня мама з ніком Ксюхрю.
Рідкісний кадр: Юлія Савічева поділилася зворушливим фото з чоловіком
32-річна співачка Юлія Савічева по праву вважається однією з найбільш таємничих вітчизняних зірок. Багато років артистка приховувала від преси свої відносини з музикантом Олександром Аршиновим, з яким вона познайомилася в далекому 2003 році.
Справжній Паваротті: шпіц Тетяни Навки виконав «Травіату»
44-річна Тетяна Навка – не тільки олімпійська чемпіонка, відома фігуристка, але і мама двох прекрасних дочок Олександри (19) і Надії (4). А також господиня забавного померанського шпіца.
Великодні яйця: 12 незвичайних способів фарбування і прикраси
Фарбувати яйця на Великдень і Червону гірку — заняття творче і дуже захоплююче. Цибулиння, термонаклейки і навіть стандартне опускання в харчовий барвник стають все менш популярними.
Стафілокок при вагітності: діагностика та лікування
Зміст:Причини поразкиТипи небезпечних бактерій для вагітних жінокСтафілокок сапрофітного типуЕпідермальний стафілококЗолотистий стафілокок у вагітнихСимптоматичні проявиВиди діагностикиЛікуванняУскладнення і прогнозСтафілокок при вагітності представляє серйозну загрозу для матері та плода при відсутності адекватної терапії або застосування народних методів лікування.
Хвороба Гіршпрунга у дітей
Зміст:Загальна характеристика хвороби ГіршпрунгаКласифікація захворювання Причини захворювання Клінічна картина Діагностика Лікування Можливі ускладненняРеабілітація Хвороба Гіршпрунга у дітей – вроджене захворювання, яке характеризує відсутність нервових сплетень в сегменті товстого кишечника.
Причини і симптоми розвитку трахеїту у дітей, методи діагностики та лікування
Зміст:Як зявляється трахеїт у дітейПричини розвитку захворюванняСимптоми захворюванняВідмінності трахеїту у дітей від інших респіраторних та інфекційних захворюваньДіагностика трахеїту у дітейЛікування захворюванняМетоди лікування в домашніх умовахПрогноз і профілактика при захворюванніТрахеїт у дітей може бути спровокований різними причинами.
Майстер-клас: робимо троянду з паперу
Папір — найпростіший матеріал для творчості, з якого можна зробити красиві і незвичайні прикраси для будь-якого свята. Навіть якщо ви ніколи не чули про мистецтво орігамі і не робили з паперу нічого складніше літачка! Пропонуємо вам простий і зрозумілий майстер-клас по створенню приголомшливою троянди з паперу, яку ви можете зробити разом з дітьми.Читайте також:Майстер-клас – робимо ляльковий будиночок своїми руками© Instagram @kanat_paper_studio, @buketoniaВам знадобиться:кольоровий папір щільна художняпістолет з термоклеємножиціолівецьлінійкаПриступаємо до виготовлення:1.
Резекція яєчника: особливості хірургічного лікування кісти
Зміст:Що таке резекція яєчника?Клиноподібна резекціяОсобливості операціїПісляопераційний періодМожливі ускладнення та наслідкиКоли можна вагітніти після резекції яєчникаРезекція яєчника – це оперативне втручання, під час якого з статевої залози вирізають ділянку тканини.
Порожні баночки листопада
Я продовжую " знищувати свої косметичні запаси» і, як і раніше, прагну до мінімалізму. Щось листопад у мене був скромний і знищення засобів сповільнилося)))...
Як лікувати гавкаючий кашель у дитини
Зміст:Особливості гавкаючого кашлюПричини появиДодаткові симптомиМетоди першої допомогиОсновна терапіяГавкаючий кашель у дитини не є самостійним захворюванням, це ознака патології дихальних шляхів або інших хвороб.
Анна Снаткіна розсекретила нового члена сімї
35-річна Анна Снаткіна — популярна актриса театру і кіно, а також щаслива дружина шоумена Віктора Васильєва і турботлива мама 5-річної Вероніки. Зіркове подружжя одружилися в жовтні 2012 у режимі повної секретності.
Спортивний уїк-енд: Павло Буре поставив дочку на ковзани
32-річна Аліна та 47-річний Павло Буре в шлюбі вже більше 10 років і виховують трьох дітей. Сина подружжя назвали, як і папу – Павлом. Імя для доньки стало певним синтезом імені мами і тата, її назвали Паліна.
Користь і застосування алое для шкіри обличчя
Зміст:Користь алое для обличчяШкода алоеЯк використовувати алое для особи?Антивікові кошти в домашніх умовахРецепти коштів з алое для зволоження і гладкість шкіриГель алое в боротьбі з чорними крапкамиСік алое можна використовувати в косметології для омолодження та поліпшення стану шкірного покриву.